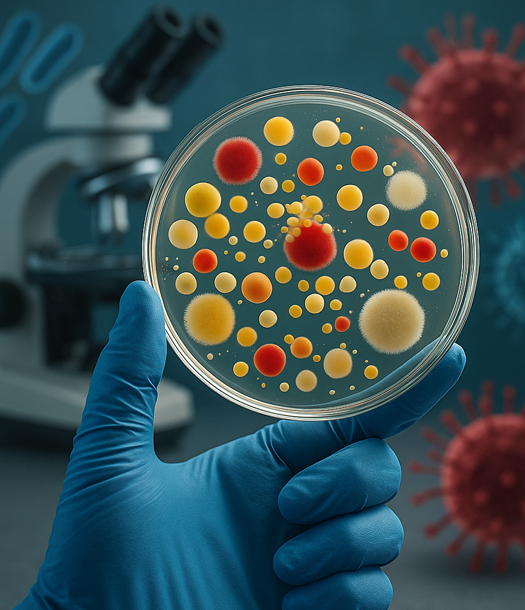

.
الأسلحة البيولوجية، في جوهرها، هي استغلالٌ سلبي وخبيثٌ لعلم الأحياء الدقيقة (Microbiology) وطبيعة الأمراض المعدية، ولا يمكن فهم طبيعة هذا السلاح، ولا جاذبيته كـ”سلاح الفقراء”، دون إدراك الأساس العلمي الذي يقوم عليه. يهدف هذا الفصل إلى تقديم المفاهيم الأساسية لعلم الأحياء الدقيقة وعلم الأمراض (Pathology) الضرورية لفهم كيفية عمل العوامل البيولوجية، وخصائصها التي تجعل بعضها مرشحاً خطيراً للتسليح، وطرق انتقالها التي تحدد فعاليتها كأسلحة.
سيتم التركيز هنا على المبادئ العامة، مع الإشارة إلى بعض الأمثلة وسيتم تفصيلها في الفصول اللاحقة بشكل موسع.
1.1 العوامل البيولوجية: أدوات المأساة المحتملة
تُصنف الكائنات الحية الدقيقة والمواد المشتقة منها التي يمكن استخدامها كأسلحة إلى فئات رئيسية:
- البكتيريا (Bacteria): كائنات دقيقة وحيدة الخلية، بعضها مُمْرِض. تتكاثر بسرعة في ظروف مناسبة. ومن الأمثلة على عوامل بكتيرية إما مستخدمة أو مرشحة للاستخدام:
- العصوية الجمرية (Bacillus anthracis): مسببة للجمرة الخبيثة (Anthrax).
- اليرسينية الطاعونية (Yersinia pestis): مسببة للطاعون (Plague).
- الفرانسييلة التولارية (Francisella tularensis): مسببة للتولاريميا (Tularemia).
- الفيروسات (Viruses): جسيمات دقيقة لا تتكاثر إلا داخل خلايا كائن حي مضيف. تتميز بتنوع كبير وقدرة على التحور السريع. أمثلة على عوامل فيروسية:
- فيروس الجدري (Variola virus): مسبب للجدري (Smallpox).
- فيروسات الحمى النزفية (مثل فيروس إيبولا Ebola virus, فيروس ماربورغ Marburg virus).
- فيروسات التهاب الدماغ (مثل فيروس فنزويلا الخيلي Venezuelan equine encephalitis virus – VEE).
- السموم البيولوجية (Biological Toxins): مركبات كيميائية سامة تنتجها كائنات حية (بكتيريا، فطريات، نباتات، حيوانات). تختلف عن العوامل الحية بعدم قدرتها على التكاثر. أمثلة على سموم:
- سم البوتولينوم (Botulinum toxin): تنتجه بكتيريا المطثية الوشيقية (Clostridium botulinum). أحد أقوى السموم المعروفة.
- الريسين (Ricin): مستخلص من بذور نبات الخروع (Ricinus communis).
- سم الساكسيتوكسين (Saxitoxin): تنتجه طحالب سامة.
- الفطريات (Fungi): كائنات يمكن أن تسبب أمراضاً للإنسان (فطريات ممرضة) أو تدمر المحاصيل. استخدمت تاريخياً كأسلحة مضادة للمحاصيل.
- الركتسيات (Rickettsiae): بكتيريا صغيرة جداً تعيش داخل الخلايا، مثل المسببة لحمى كيو (Coxiella burnetii).
1.2 خصائص العوامل البيولوجية المناسبة للتسليح: معايير الاختيار
ليس كل مُمْرِض أو سم مناسب ليكون سلاحاً بيولوجياً فعالاً. العوامل المرغوبة تمتاز بمزيج من الخصائص التالية (ليس بالضرورة جميعها معاً):
- الفتك العالي أو القدرة على الإعاقة الشديدة (High Virulence/Potency)
قدرة العامل على إحداث مرض شديد أو الموت في نسبة عالية من المصابين (مثل الجمرة الخبيثة الاستنشاقية، الجدري، إيبولا). للسموم، تعني السمية العالية (قلة الجرعة المميتة LD50).
- قابلية الانتقال (Transmissibility):
سهولة انتقال العامل من شخص لآخر (مثل الجدري، الطاعون الرئوي) أو عبر وسيط (ماء، غذاء، نواقل). بعض الأسلحة البيولوجية تهدف للإعاقة دون نقل العدوى (مثل الجمرة الخبيثة الجلدية غالباً، التولاريميا، معظم السموم).
- فترة حضانة مناسبة (Incubation Period):
الفترة بين التعرض للعامل وظهور الأعراض. الفترة “المناسبة” تعتمد على الهدف:
- فترات قصيرة نسبياً (1-6 أيام) للعمليات العسكرية المباشرة (مثل التولاريميا، معظم السموم).
- فترات أطول (1-2 أسبوع أو أكثر) قد تكون مفيدة لنشر المرض دون ربط فوري بالهجوم (مثل الجمرة الخبيثة الاستنشاقية).
- الثبات (Stability):
قدرة العامل على البقاء حياً وفعالاً لفترة كافية في البيئة (خارج المضيف) أو أثناء تخزينه وتطايره. عوامل مثل الجمرة الخبيثة (في صورة جراثيم) والسموم (مثل البوتولينوم المجفف بالتجميد) عالية الثبات. الفيروسات مثل الجدري معتدلة الثبات.
- قابلية الإنتاج بكميات كبيرة (Producibility):
إمكانية زراعة العامل أو تصنيعه بكميات كبيرة باستخدام تقنيات وتجهيزات متاحة نسبياً. البكتيريا أسهل إنتاجاً من الفيروسات في الغالب.
- قابلية الانتشار الفعال (Deliverability):
إمكانية تحويل العامل إلى شكل يمكن نشره بفعالية (مثل رذاذ جوي – aerosol للاستنشاق، أو مسحوق، أو سائل لتلويث الماء/الغذاء).
- عدم توفر لقاحات أو علاجات فعالة وسهلة التوزيع (Lack of Effective Countermeasures):
يزيد من جاذبية العامل للجهات المهاجمة، حيث يصعب الدفاع ضده.
- المقاومة للبيئة والعلاجات (Resilience):
مقاومة بعض العوامل للعوامل البيئية (أشعة الشمس، الجفاف) أو للمضادات الحيوية/مضادات الفيروسات (سواء طبيعياً أو عبر الهندسة).
1.3 طرق انتقال العدوى: بوابات الغزو
تحدد طريقة دخول العامل البيولوجي إلى الجسم مسار المرض وفعالية السلاح. الطرق الرئيسية لدخول الميكروبات أو منتجاتها:
- الاستنشاق (Inhalation):
الأكثر فعالية وخطورة للتسليح. يتطلب تحويل العامل إلى جزيئات دقيقة جداً (aerosol) تبقى عالقة في الهواء وتستنشق لتصل إلى الرئتين. فعال للغاية مع:
- الجمرة الخبيثة (الاستنشاقية قاتلة بنسبة عالية).
- الطاعون الرئوي.
- التولاريميا.
- الجدري.
- فيروسات الحمى النزفية.
- العديد من السموم (مثل البوتولينوم، الريسين إذا استنشق).
التحدي التقني الرئيسي للجهات محدودة الموارد هو إنتاج رذاذ فعال ومستقر.
- الابتلاع (Ingestion):
تلويث مصادر الماء أو الغذاء بالعامل. مناسب للعوامل التي تهاجم الجهاز الهضمي مثل:
- الكوليرا، التيفوئيد، الشيغيلا (زحار).
- السموم (مثل الريسين، البوتولينوم، الساكسيتوكسين).
- الجمرة الخبيثة (نادرة نسبياً عبر هذا الطريق). أسهل تقنياً من الاستنشاق، لكن قد يكون تأثيره أبطأ وأقل انتشاراً.
- الامتصاص عبر الجلد أو الأغشية المخاطية (Dermal/Mucosal Absorption):
- الاتصال المباشر مع الجلد: فعال مع الجمرة الخبيثة الجلدية (إذا كان الجلد مجروحاً)، الجمرة الخبيثة المعدية المعوية (نادر)، وبعض السموم.
- العينان أو الأنف أو الفم: يمكن أن تكون مداخل، خاصة للرذاذ أو المواد الملوثة. يقلل من فعالية السلاح مقارنة بالاستنشاق، لكن قد يحدث مع التلوث البيئي الواسع.
- الحقن (Injection):
أقل شيوعاً في الهجمات واسعة النطاق، لكنه ممكن في الاغتيالات أو الهجمات المحدودة باستخدام المحاقن أو الشظايا الملوثة. فعال للسموم مثل الريسين.
- النواقل الحيوية (Vectors):
استخدام حشرات (براغيث، بعوض، قراد) أو قوارض مصابة لنشر المرض. تاريخياً مهم للطاعون (البراغيث). صعب التحكم فيه بدقة وقد ينقلب ضد القوة المهاجمة.
1.4 مسار المرض: من التعرض إلى النتيجة
بعد دخول العامل البيولوجي الجسم عبر إحدى البوابات، يسلك مساراً عاماً:
- التعرض (Exposure): الاتصال مع العامل.
- فترة الحضانة (Incubation Period):
الوقت بين التعرض وظهور الأعراض. خلالها يتكاثر العامل وينتشر في الجسم دون أعراض ظاهرة. فترة حرجة للغاية في الحرب البيولوجية، فهي تعطي مهلة للعدوى بالانتشار وتجعل ربط المرض بالهجوم صعباً.
- المرحلة البادرية (Prodromal Phase):
ظهور أعراض عامة غير نوعية مثل الحمى، القشعريرة، الصداع، آلام العضلات، الغثيان. تشبه أعراض الإنفلونزا. تزيد من صعوبة التشخيص المبكر.
- المرحلة النوعية (Specific-Illness Phase):
ظهور الأعراض المميزة للمرض (مثل الطفح الجلدي في الجدري، ضيق التنفس والنزف في الحمى النزفية، الشلل في البوتوليزم).
- النتيجة (Outcome):
الشفاء (قد يكون مصحوباً بعواقب طويلة الأمد)، الإعاقة الدائمة، أو الوفاة. يعتمد على شدة العامل، الجرعة، طريقة التعرض، والحالة الصحية للمصاب، وتوفر العلاج.
1.5 الأساس البيولوجي لـ “سلاح الفقراء”: لماذا تتناسب البيولوجيا مع محدودية الموارد؟
يبدأ فهم فكرة “السلاح البيولوجي كسلاح الفقراء” من خصائص العوامل البيولوجية نفسها وعلومها:
المواد الخام في الطبيعة:
العديد من مسببات الأمراض الخطيرة (كالجمرة الخبيثة، الطاعون، التولاريميا) موجودة بشكل طبيعي في التربة أو الحيوانات. السموم مثل الريسين مستخرجة من نبات شائع. لا يتطلب الحصول على المادة الأولية بنية تحتية نووية معقدة.
المعرفة العلمية متاحة:
المبادئ الأساسية لعلم الأحياء الدقيقة وتقنيات المختبر متاحة في الكتب الجامعية والدوريات والإنترنت. لا تتطلب معرفة سرية أو عالية التخصص كتلك اللازمة للأسلحة النووية.
التقنيات الأولية قد تكفي:
بينما يتطلب إنتاج عوامل عالية النقاء وفعالة في الانتشار الاستنشاقي تقنيات متقدمة، فإن إنتاج كميات من العوامل أقل نقاءً لأغراض التلويث المحدود (المياه، الغذاء) أو استخدام السموم البسيطة يمكن تحقيقه بمختبرات أولية.
صعوبة الكشف والتمييز:
يصعب اكتشاف هجوم بيولوجي في مراحله المبكرة (فترة الحضانة، الأعراض الأولية غير النوعية). يمكن خلط العامل المسلح مع تفشي طبيعي للمرض. يمنح الجهة المهاجمة إنكاراً معقولاً ويجعل الرد صعباً.
تأثير نفسي واقتصادي غير متناسب:
حتى الهجمات الصغيرة أو الفاشلة يمكن أن تسبب ذعراً واسعاً وتعطيلاً اقتصادياً كبيراً. التكلفة المنخفضة مقابل التأثير المحتمل العالي جاذبة.
وهنا نوجز
يوفر علم الأحياء الدقيقة وعلم الأمراض الأساس المادي للتهديد البيولوجي. فهم طبيعة العوامل الممرضة (بكتيريا، فيروسات، سموم)، الخصائص التي تجعلها مناسبة للتسليح (الفتك، القابلية للانتشار، الثبات)، وطرق انتقالها (الاستنشاق، الابتلاع، التلامس) هو الخطوة الأولى لفك طبيعة هذا السلاح المعقد. تكمن جاذبية الأسلحة البيولوجية للجهات محدودة الموارد جزئياً في هذه الخصائص البيولوجية نفسها: توفر المواد الخام في الطبيعة، وصول نسبي للمعرفة العلمية الأساسية، وإمكانية تحقيق تأثير مدمر (أو على الأقل تعطيل هائل) بتكلفة وتقنية أقل بكثير من الأسلحة التقليدية أو النووية المتطورة. يشكل هذا الأساس العلمي اللبنة الأولى لفهم فصول الكتاب القادمة، التي ستتناول التاريخ، العوامل المحددة، الجوانب العملية للتسليح، واستراتيجيات المواجهة.
.
المراجع
- Kortepeter, M. G., Parker, G. W. (Eds.). (2017). Biological Warfare: A Historical Perspective.
- Medical Aspects of Biological Warfare. Office of The Surgeon General.
- Deadly Cultures: Biological Weapons since 1945. Harvard University Press.
- The Chilling True Story of the Largest Covert Biological Weapons Program in the World
- Preston, R. (2002). The Demon in the Freezer: A True Story. Random House
- National Academies of Sciences, Engineering, and Medicine. (2018).
- Riedel, S. (2004). Biological warfare and bioterrorism: a historical review.
- Atlas, R. M. (2002). Bioterrorism: From threat to reality.
- Public health response to biological and chemical weapons: WHO guidance.
- US Centers for Disease Control and Prevention (CDC). Emergency Preparedness and Response.
- Murray, P. R., Rosenthal, K. S., Pfaller, M. A. (2021). Medical Microbiology (9th ed.). Elsevier.
- Ryan, K. J. (Ed.). (2017). Sherris Medical Microbiology (7th ed.).
- Mandell, Douglas, and Bennett’s Principles and Practice of Infectious Diseases.
.
تواصل مع الكاتب: elmanama_144@yahoo.com